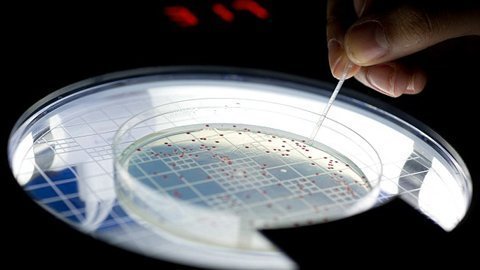
Hồi sinh vi khuẩn 500 triệu năm tuổi

Tìm kiếm: vi-khuẩn-e-coli
Trung bình, mỗi người dành khoảng 3 tháng cuộc đời trong nhà vệ sinh. Dù muốn hay không, việc đi vệ sinh là một phần quan trọng nhưng có một lỗi phổ biến nhiều người thường mắc phải là không đậy nắp bồn cầu khi xả nước.
Các nhà nghiên cứu đã phục dựng một gene cổ đại có tuổi đời lên tới 500 triệu năm và cấy nó vào cơ thể vi khuẩn E Coli hiện đại.
Rửa rau không nên dùng nước muối là điều mà ít bà nội trợ biết đến.
Viêm bàng quang chủ yếu do nhiễm trùng đường tiết niệu gây ra, bệnh hoàn toàn có thể được trị dứt điểm bằng các nguyên liệu có sẵn từ thiên nhiên dưới đây.
Theo một cuộc khảo sát gần đây, rất nhiều người nghiện điện thoại đến mức sử dụng ngay cả khi ở trong… nhà vệ sinh. Thói quen này không chỉ có hại cho sức khỏe mà còn ảnh hưởng đến tinh thần mỗi người.
Rau mầm, sữa tươi, trứng, hàu...đều là những thực phẩm ngon miệng và giàu chất dinh dưỡng. Thế nhưng, nếu nấu không đúng cách sẽ rất dễ dàng khiến bạn mang bệnh vào người.
Federica Bertocchini, nhà khoa học ở Đại học Cantabria (Tây Ban Nha) đã phát hiện khả năng ăn rác thải nhựa đáng kinh ngạc của sâu sáp khi đang chăm sóc tổ ong.
Cháo lòng, lòng lợn vốn là món ăn được khá nhiều người ưa thích. Tuy nhiên đây không phải là món ăn 'vô hại' đối với tất cả mọi người, bởi món ăn này có 'đại kỵ' mà không phải ai cũng biết.
Thớt gỗ vốn là dụng cụ hữu dụng của nhà bếp. Sau một thời gian sử dụng, những chiếc thớt gỗ sẽ dần có mùi, các vệt mốc sẫm màu vừa xấu xí vừa ảnh hưởng tới sức khỏe.
Làm ra được những món ăn ngon, khỏe mạnh thì điều kiện tiên quyết là phòng bếp luôn phải sạch sẽ, ngăn nắp. Để làm được điều đó, bạn nên tránh đặt, lưu trữ 3 thứ trong phòng bếp, nếu không chúng sẽ ảnh hưởng đến môi trường bếp và cả sức khỏe của bạn.
Một số loại thực phẩm cần phải được nấu chín kỹ, không nên ăn sống hay tái để tiêu diệt các loại vi khuẩn, độc tố gây nguy hại cho cơ thể con người.
Theo các nhà nghiên cứu Trung Quốc, thói quen lấy khăn lau khô bát đũa ngay sau khi rửa xong là một sai lầm nghiêm trọng cần loại bỏ.
Cho tới hiện tại, các nhà thiên văn học vẫn đang cố gắng săn lùng sự sống ngoài hành tinh bằng cách tìm kiếm dấu hiệu hóa học đặc trưng của chúng. Tuy nhiên, giới nghiên cứu tuyên bố đã phát hiện ra một cách tìm kiếm tốt hơn, thông qua các dao động.
Hạn sử dụng của 5 dụng cụ làm bếp nhà nào cũng có, không nên tiếc của dùng mãi mà rước bệnh vào thân
Sau khi sử dụng một thời gian, những dụng cụ nhà bếp này sẽ "hết hạn sử dụng". Bạn nên thay mới chúng để bảo vệ sức khỏe cho gia đình.
Lòng lợn và các nội tạng động vật là thực phẩm giàu chất béo, cholesterol nên không phù hợp với nhiều đối tượng.
End of content
Không có tin nào tiếp theo